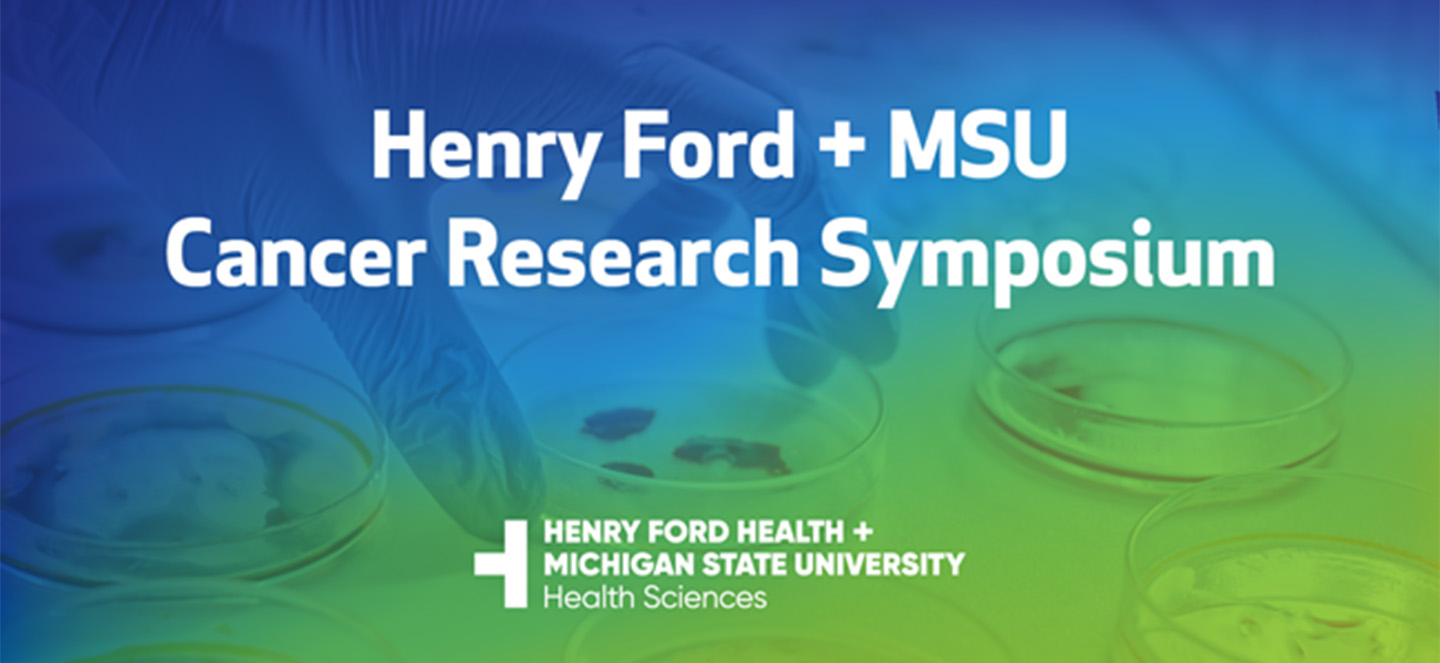
Henry Ford + MSU Cancer Resaerch Symposium Graphic

Ask the Expert: How Can Your Address Affect Your Risk of Lung Cancer?
New MSU research shows that where you live can significantly affect your risk of developing and dying from lung cancer. People in rural or persistently poor communities face higher risks due to greater exposure and limited access to care.

Chasing Circles To Cure Cancer
Assistant professor Eunhee Yi is exploring how extrachromosomal circular DNA drives cancer progression and drug resistance. Yi’s current research focuses on melanoma, an aggressive form of skin cancer. With support from the Pardee Foundation, her lab is developing a longitudinal model system to track ecDNA formation and perform multi-omics analysis to understand how it drives drug resistance. Additionally, her lab aims to identify drugs that specifically target ecDNA-containing cancer cells.
5th Annual Henry Ford + MSU Cancer Research Symposium
The 5th Annual Henry Ford + MSU Cancer Research Symposium aims to bring together researchers, clinicians, trainees, and health care professionals from Michigan State University and Henry Ford Health to explore the future of integrated cancer research.

MSU's Federally Funded Cisplatin Cancer Drug Wins National Award
On Sept. 16, Michigan State University received a national honor — the 2025 Golden Goose Award for the scientific success and global impact of cisplatin, the gold standard of cancer-fighting chemotherapy treatments.

MSU Scientists Give Spartan Family Hope Against Brain Cancer
An NIH-funded discovery at MSU may offer new hope against glioblastoma, the deadliest form of brain cancer. But cuts to federal research funding now threaten progress for families counting on breakthroughs like this.

MSU’s Cisplatin Cancer Drug Wins National Award
As announced today, MSU will receive a 2025 Golden Goose Award for the scientific success and global impact of cisplatin. The Golden Goose Award is meant to highlight the practical value of curiosity-driven research.

Shampoo-Like Gel Could Help Chemo Patients Keep Their Hair
Cancer fighters know that losing their hair is often part of the battle, but Michigan State University researchers have developed a shampoo-like gel that has been studied in animal models and could protect hair from falling out during chemotherapy treatment.

Ask the Expert: How To Prevent Cervical Cancer
Julie Thomas-Beckett is a nurse practitioner who specializes in preventative and holistic care at MSU. Here, she discusses the importance of cervical cancer screenings and the latest information regarding cervical health in advance of Gynecologic Cancer Awareness Month in September.

How Cancer Research is Funded and What Happens When It's Cut
Cancer research in the U.S. is backed by a complex system of interdependent funding. Partners include academia, pharmaceutical companies, biotechnology start-ups, federal agencies and private foundations. These groups rely heavily on each other and, when one struggles, the entire system suffers.

Michigan State University Flint Community Cancer Consortium Launches Cancer Feasibility Study
People in Flint are concerned about elevated cancer rates, particularly multiple myeloma, and possible links to environmental exposures where they live, work, and play. For many in the community, a lack of high-quality reporting on cancer rates in the wake of the Flint water crisis can be highly distressing, worrisome, and frustrating.

New $3M NIH Grant Supports Henry Ford + MSU Researchers Studying HPV-Positive Head and Neck Cancers
Researchers from Henry Ford Health + Michigan State University Health Sciences have been awarded a $3 million grant from the National Institute of Dental and Craniofacial Research to study new treatments for patients who have head and neck cancer caused by the human papillomavirus, or HPV.

American Cancer Society Grant Fuels Colorectal, Breast and Cervical Cancer Research
Four dedicated researchers from Michigan State University have received grants totaling more than $3 million from the American Cancer Society, or ACS, to find new ways to prevent, detect, treat and help patients survive colorectal, breast and cervical cancer.

